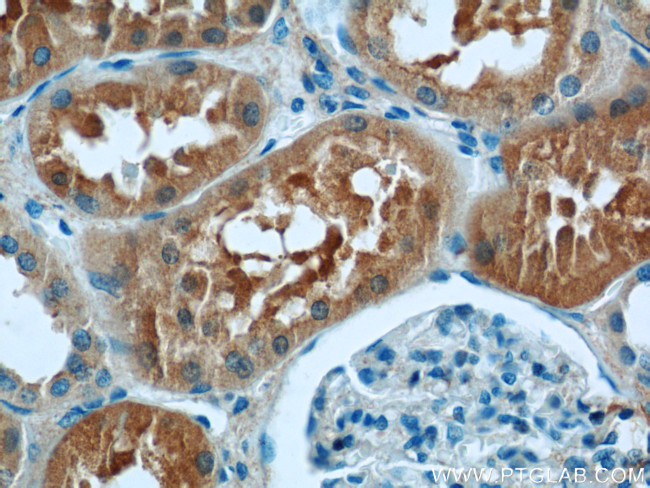
VAMP3/Cellubrevin Antibody in Immunohistochemistry (Paraffin) (IHC (P))
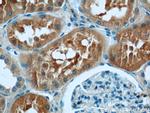
VAMP3/Cellubrevin Antibody in Immunohistochemistry (Paraffin) (IHC (P))
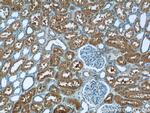
VAMP3/Cellubrevin Antibody in Immunohistochemistry (Paraffin) (IHC (P))

Search
Proteintech
VAMP3/Cellubrevin Polyclonal Antibody
{{$productOrderCtrl.translations['antibody.pdp.commerceCard.promotion.promotions']}}
{{$productOrderCtrl.translations['antibody.pdp.commerceCard.promotion.viewpromo']}}
{{$productOrderCtrl.translations['antibody.pdp.commerceCard.promotion.promocode']}}: {{promo.promoCode}} {{promo.promoTitle}} {{promo.promoDescription}}. {{$productOrderCtrl.translations['antibody.pdp.commerceCard.promotion.learnmore']}}
产品信息
10702-1-AP
种属反应
已发表种属
宿主/亚型
分类
类型
抗原
偶联物
形式
浓度
规格
纯化类型
保存液
内含物
保存条件
运输条件
产品详细信息
Immunogen sequence: MSTGPTAAT GSNRRLQQTQ NQVDEVVDIM RVNVDKVLER DQKLSELDDR ADALQAGASQ FETSAAKLKR KYWWKNCEMW AIGITVLVIF IIIIIVWVVS (1-99 aa encoded by BC005941 )
靶标信息
Synaptobrevins/VAMPs, syntaxins, and the 25-kDa synaptosomal-associated protein are the main components of a protein complex involved in the docking and/or fusion of synaptic vesicles with the presynaptic membrane. This gene is a member of the vesicle-associated membrane protein (VAMP)/synaptobrevin family. Because of its high homology to other known VAMPs, its broad tissue distribution, and its subcellular localization, the protein encoded by this gene was shown to be the human equivalent of the rodent cellubrevin. In platelets the protein resides on a compartment that is not mobilized to the plasma membrane on calcium or thrombin stimulation.
仅用于科研。不用于诊断过程。未经明确授权不得转售。
生物信息学
蛋白别名: CEB; Cellubrevin; Synaptobrevin-3; unnamed protein product; vamp; VAMP-3; VAMP3; Vesicle-associated membrane protein 3
基因别名: CEB; D130027G05Rik; SYB3; VAMP-3; VAMP3
UniProt ID: (Human) Q9BRV4, (Mouse) P63024, (Rat) P63025
Entrez Gene ID: (Human) 9341, (Mouse) 22319, (Rat) 29528